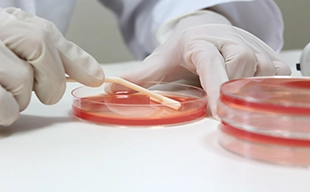

化学業界での仕事例

化学物質の理化学試験・分析およびデータ解析

電子材料・機能性材料の試作および特性分析

有機・無機材料の研究開発における合成および評価業務

工業化検討に伴うプロセス評価および品質確認
化学業界の取引法人一例
三菱ケミカル/住友化学/三井化学/旭化成/ENEOS/出光興産/AGC/富士フイルム/積水化学工業/東レ(敬称略・順不同)
医薬品業界での仕事例

分析機器(HPLC等)を用いた医薬品の品質試験・分析業務

医薬品開発におけるバイオ実験(細胞培養・遺伝子解析・動物試験 等)

体外診断用医薬品の研究開発および評価

創薬研究における薬効評価および作用機序解析
医薬品業界の取引法人一例
武田薬品工業/第一三共/アステラス製薬/エーザイ/大塚製薬/中外製薬/協和キリン/小野薬品工業/ベーリンガーインゲルハイム製薬/ファイザー・ファーマ(敬称略・順不同)
食品業界での仕事例

食品・機能性素材の研究開発における試験・分析業務
微生物試験・理化学試験による品質評価

成分分析および分析手法の開発・改良

食品原料・酵素製剤の開発および製造プロセス検討
食品業界の取引法人一例
味の素/日本たばこ産業/キリンホールディングス/サッポロビール/J-オイルミルズ/理研ビタミン/ウェルネオシュガー/オリエンタル酵母工業/ダスキン(敬称略・順不同)




























































































































